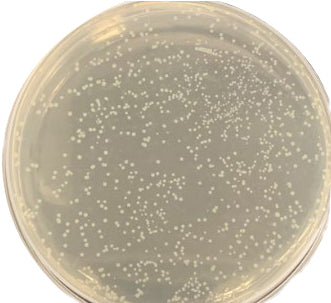

Антибактериальная нержавеющая сталь
Ag > Hg > Cu > Cd > Cr > P b > Co > Au > Zn > Fe > Mn > Mo > Sn

Преимущества:
● Из всех металлов антибактериальная способность серебра самая сильная, примерно в 100 раз выше, чем у меди.
● Имеют более широкий антибактериальный спектр, могут убить больше видов болезнетворных бактерий.
● Добавьте менее одной десяти меди, нержавеющая сталь немного повлияет на производительность исходного уровня.
● Серебро и железо являются несмешивающимися элементами типичной системы, практически не растворимы ни в жидком, ни в твердом состоянии.
● Существующий процесс литья позволяет легко производить сегрегацию серебряных элементов, улучшение процесса термообработки очень ограничено.
● Антибактериальные свойства нестабильны, процесс термообработки требует высоких энергозатрат, эффект не очевиден, его сложно использовать в промышленном производстве.
● Благодаря добавлению соединения серебра в сырье, разложение соединения в процессе спекания приводит к образованию дисперсных частиц серебра.
● Отличные антибактериальные свойства, антибактериальность выше 99%.
● Стабильная антибактериальная способность, частицы серебра распределяются равномерно.
● Обладает постоянной антибактериальной способностью, не боится царапин и порезов.

Порошковая металлургия, серебряный подшипник, нержавеющая сталь 316L (слева)
Результаты прошлых антибактериальных испытаний нержавеющей стали 316L на содержание серебра (в центре)
Серебросодержащая нержавеющая сталь (справа)
Результаты антибактериального теста
Диаграмма состояния Ag – Fe показывает, что Ag – Fe нерастворимо в твердом состоянии и не образует интерметаллических соединений.

● Использование литья под давлением порошка не может решить проблему смешиваемости серебра с железом.
● Наноразмерные частицы серебра равномерно распределены по подложке из нержавеющей стали и обеспечивают хорошие антибактериальные свойства.
● Добавляйте только следы серебра, это не повлияет на характеристики нержавеющей стали и не приведет к значительному увеличению стоимости нержавеющей стали.
● Возможно изготовление различных типов антибактериальной нержавеющей стали.
Если у вас есть вопросы, вы всегда можете связаться с нами. Мы ответим вам как можно скорее, в течение 24 часов в будние и выходные дни.
Поддержка клиентов
Ваше удовлетворение — наш приоритет.
Мы предлагаем комплексную пожизненную техническую поддержку и гарантийное обслуживание .
Связаться с нами
WhatsApp: +86 180 0255 3024
Электронная почта: market@mim-supplier.com
Информация о доставке
Обычно мы отправляем вам образцы через DHL, FedEx или UPS.
Оптовые грузы будут доставляться морем для экономии транспортных расходов.
Часто задаваемые вопросы
Какие материалы вы предоставляете?
Мы предлагаем широкий ассортимент материалов для порошковой металлургии.
MIM: нержавеющая сталь 304 316 420 17-4, титановые сплавы TC4 TA2, никель-хром-железные сплавы AISI 310S
Процесс CIM: цирконий, оксид алюминия, нитрид кремния, карбид кремния и нитрид алюминия
Наша команда по исследованиям и разработкам может разработать индивидуальные материалы, отвечающие конкретным требованиям вашего применения.